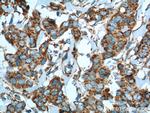
Cytochrome c Antibody in Immunohistochemistry (Paraffin) (IHC (P))
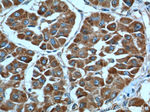
Cytochrome c Antibody in Immunohistochemistry (Paraffin) (IHC (P))
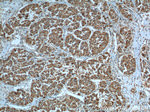
Cytochrome c Antibody in Immunohistochemistry (Paraffin) (IHC (P))

Search
Proteintech
Cytochrome c Monoclonal Antibody (2D8D11)
{{$productOrderCtrl.translations['antibody.pdp.commerceCard.promotion.promotions']}}
{{$productOrderCtrl.translations['antibody.pdp.commerceCard.promotion.viewpromo']}}
{{$productOrderCtrl.translations['antibody.pdp.commerceCard.promotion.promocode']}}: {{promo.promoCode}} {{promo.promoTitle}} {{promo.promoDescription}}. {{$productOrderCtrl.translations['antibody.pdp.commerceCard.promotion.learnmore']}}
产品信息
66264-1-IG
种属反应
已发表种属
宿主/亚型
分类
类型
克隆号
抗原
偶联物
形式
浓度
规格
纯化类型
保存液
内含物
保存条件
运输条件
产品详细信息
Immunogen sequence: MGDVEKGKK IFIMKCSQCH TVEKGGKHKT GPNLHGLFGR KTGQAPGYSY TAANKNKGII WGEDTLMEYL ENPKKYIPGT KMIFVGIKKK EERADLIAYL KKATNE (1-105 aa encoded by B C009578)
靶标信息
Cytochrome C is an electron transporting protein that resides within the intermembrane space of the mitochondria, where it plays a critical role in oxidative phosphorylation and the production of cellular ATP. Release of cytochrome C from the mitochondria to the cytosol is triggered by apoptotic stimuli. In the cytoplasm, the cytochrome C binds apoptotic protease activating factor which activates the apoptotic initiator procaspase 9. Cytosolic cytochrome C functions in the activation of caspase 3, an ICE family molecule that is a key effector of apoptosis.
仅用于科研。不用于诊断过程。未经明确授权不得转售。
生物信息学
蛋白别名: APOCYTOCHROME C-A; AT1G22840; AT4G10040; ATCYTC-A; CRF; CYCS; CYTC-1; CYTC-2; Cytochrome c; Cytochrome C, expressed in somatic tissues; Cytochrome c, somatic; CYTOCHROME C-1; CYTOCHROME C-2; CYTOCHROME C-A; F19G10.20; F19G10_20; hc1; T5L19.170; T5L19_170; unnamed protein product
基因别名: CYC; CYCS; CYCSA; HCS; THC4
UniProt ID: (Human) P99999, (Mouse) P62897, (Rat) P62898
Entrez Gene ID: (Human) 54205, (Mouse) 13063, (Rat) 25309